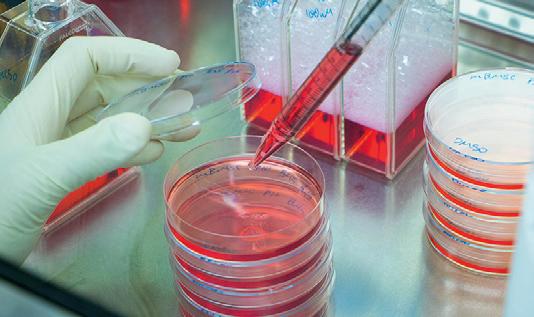
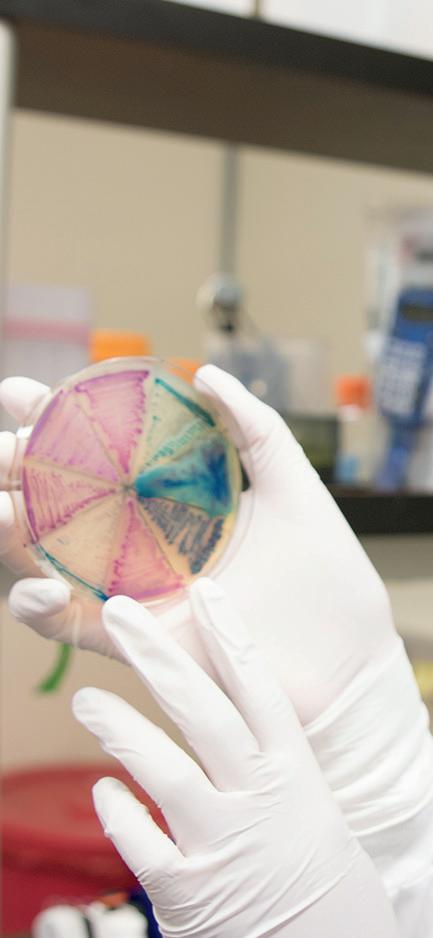

![]()






Hello, Dunlop BioSci Anteaters!
Welcome to UC Irvine Charlie Dunlop School of Biological Sciences and congratulations! You are among the very select group of students who were accepted and enrolled here from over 140,000 who applied to the University this academic year. Futhermore, you are pursuing what we believe is the most important, exciting and meaningful scientific focus: the study of life. You have chosen to help shape the future of humanity and our planet.

MIND | BODY | WORLD is our School’s foundational theme. You will see these three words frequently on campus and in our print and digital communications. Everything in our world begins with life. And life is interconnected. For most of us, a healthy mind requires a healthy body, which in turn requires a healthy world. With the global challenges society faces that impact our health, our economy, and our world every day, audacious biology has never been more urgent. As you begin your studies, you are on your way toward becoming an innovator who can help make a powerful difference in health, climate change, energy production, agriculture and much more.
In entering Dunlop BioSci, you join the sole biology school in Orange County at the R1, or highest research activity level. We are the premier life sciences institution here that is creating new knowledge. As an undergraduate, you bring intellect and energy that help power our mission in shaping the world for the better. Embrace the challenge and enjoy the wonderful satisfaction of achievement.
Please take advantage of everything the School and the University offer to further your success. I look forward to getting to know you in coming months.
Sincerely,
Frank M. LaFerla, PhD
Dr. Lionel and Fay Ng Dean and Distinguished Professor
“Explore all the possibilities.”

It’s a great pleasure to welcome you to UC Irvine Charlie Dunlop School of Biological Sciences. As you settle in here, you will find we are a community of people passionate about biology’s leading role in solving life’s most compelling issues, from climate change to human health. Your education here will launch you on the path of your dreams and prepare you to help shape a better world for all who inhabit it.
I encourage you to take advantage of all the resources UC Irvine Charlie Dunlop School of Biological Sciences offers to help you succeed, such as academic counseling, peer tutoring, mentorships, networking and much more. We hope you explore the spectrum of possibilities open to you to achieve your full potential.
Please also take time to play as well as work. Check out the array of activities across campus. Friendships, exercise and fun are essential to a healthy life; they refresh and recharge you for your studies. Remember, too, that the Dunlop BioSci Student Affairs Office is here to answer your questions and provide assistance.
Best wishes as you begin your first year here and see you around Dunlop BioSci!
Yours truly,
Raju Metherate, PhD Associate Dean of Undergraduate Education
UC Irvine Charlie Dunlop School of Biological Sciences

Dunlop BioSci Student Affairs is here to help you have a productive and positive college experience. We work with you to help you develop the skills and knowledge you need to navigate UC Irvine and work toward achieving your goals. Beyond clarifying requirements and policies, we help students connect with resources and opportunities, work through challenges, and make good decisions to support your academic success.
You met your Dunlop BioSci Advisors through summer orientation. New students will see us again in freshman and transfer seminars this fall. Watch for our workshops if you hope to study abroad, need help with academic success, or want pre-health guidance. And we’d love to say hi at one of the student engagement activities we host this year to help you destress and connect with your Bio community.
Working with your professional Advisors, the Dunlop BioSci Peer Academic Advisors (PAAs) are an amazing group of students with experience and expertise to share. They’re great at answering advising questions and providing guidance from a student perspective.
UC Irvine offers many great opportunities, and many students will run into challenges. You don’t need to figure it out alone – your Bio Advisors and PAAs are here to help you understand your options, connect with opportunities, and navigate challenges.
We invite you to check out our website, where you can ask quick questions through our online chat, schedule longer conversations through UC Irvine Appointments, and find helpful forms, policies, and info.
undergraduate.bio.uci.edu/student-affairs/



BIOCHEMISTRY & MOLECULAR BIOLOGY EXERCISE SCIENCES

DEVELOPMENTAL & CELL BIOLOGY GENETICS
As a Dunlop BioSci undergraduate, you study the science of life and the interconnection between mind, body and world health. As you learn more about the extraordinary ways biologists shape the future, you may become intrigued by a particular area and decide to choose it as a major.
Students begin by majoring in Biological Sciences, Ecology & Evolutionary Biology or Biology/Education. After meeting course and GPA requirements, it’s possible to apply for these additional majors:



For more info on Dunlop BioSci majors and the Change of Major process, please see undergraduate. bio.uci.edu/change-of-major/




undergraduate.bio.uci.edu/clubs-andorganizations-2024/


As you hit the books in coming weeks, there’s a special resource to help if you have questions on a particular course or would like more explanation of a concept. UCI Dunlop BioSci Peer Tutoring is designed to assist you in exactly this situation, and it’s free!
The weekly sessions are led by upperclass students who have excelled in the subjects you are studying. They cover key points of individual classes, provide worksheets so you can practice that week’s material and hold review sessions before exams. It’s an atmosphere of camaraderie and encouragement. The program’s tutors say they love seeing students learn and succeed.
One undergraduate who attended Peer Tutoring said, “It really helped me understand concepts I didn’t grasp at first. Because of it, I felt I did better on my midterm scores and quiz scores.”
Another participant commented, “My tutor created a comfortable environment. I got more exposure and extra help on the material.”
There’s no need to sign up in advance. You can go to just one session or all of them; prior attendance is not necessary. For more information, visit:
https://sites.google.com/a/uci.edu/biotutor/



“Our greatest weakness lies in giving up. The most certain way to succeed is always to try just one more time.”
– Thomas A. Edison

“You have to stay in school. You have to. You have to go to college. You have to get your degree... the one thing people can’t take away from you is your education. And it is worth the investment.”
– Michelle Obama





What do eating a donut, spending time with alumni and getting an insider’s insights into hot biology topics have in common? They are all ways you can jump start your future plans now by networking. Please check out the many opportunities to get to know School faculty and leadership, Dunlop BioSci grads and acclaimed biologists from around the world. Here are just a few we suggest:

• DONUTS WITH THE DEAN:
Meet up with Dunlop BioSci Dean Frank LaFerla and life sciences professionals at this casual quarterly get-together. Enjoy lively conversation sweetened by your choice of powdered, glazed and more. Yum!
• MENTOR PROGRAM:
Register to be matched with an alumnus or alumna, or another community professional, who works in the life sciences and shares your field of focus. You’ll benefit from expert advice and encouragement as you work toward your goals.
• LECTURES:
Attend the Dean’s Distinguished Lecture Series. BioSci faculty and other acclaimed scientists will fill you in on the newest developments on pressing biological and medical topics. Ask questions and mingle afterwards. You’ll come away with greater insights and new professional links.
• STARBUCKS:
Keep in mind Dunlop BioSci Starbucks is a favorite networking venue. The café, located in Mitosis Plaza across from BioSci 3, seems to have a special way of energizing conversation and connections, and we don’t think it’s just the caffeine!
For more info on getting involved with the Dunlop BioSci community, explore undergraduate.bio.uci.edu/get-involved/



Participation in the Excellence in Research Program is among the highest academic achievements for UC Irvine undergraduates. To successfully complete the program, participants must:
• Enroll in Bio Sci 199 for 4 quarters.
• Complete a scientific paper.
• Present a research poster.
For complete eligibility requirements, please visit: undergraduate.bio.uci.edu/undergraduate-excellence-in-research-program/
• Mentorship from world-class faculty and scientists.
• Publish your research in a scientific journal.
• Distinguish your post-graduation applications and interviews.
• Sharpen your critical thinking, writing and oral communication skills.
• Participate in a research symposium.
Those who successfully complete the program are awarded the “Excellence in Research” designation, and their papers are published in the Journal of Undergraduate Research in the Biological Sciences. Through these opportunities, our students gain a depth of understanding and appreciation for research at the highest level that cannot be obtained in any other way.

Poster Judging 2018 – Christy Munson presents poster (Bio 199 Behavioral Neurosci, Sean Ostlund).

November Information Workshops – Student panelists share their experience in the program with interested students.
Need more information?
Please visit the BioSci Student Affairs website at: undergraduate.bio.uci.edu/undergraduate-excellence-in-researchprogram/
The UC Irvine Charlie Dunlop School of Biological Sciences established the Outreach, Research Training and Minority Science Programs (MSP) in 2000 to increase the number and academic excellence of underrepresented (UR) groups being trained as the next generation of biomedical research scientists. With help from the National Institutes of Health (NIH), MSP supports programs that foster research training and the development of a strong and diverse biomedical research workforce.
MSP uses a “pipeline” approach to identify promising undergraduate students early in their academic careers (freshman and sophomore students) to foster an interest in research to ultimately enter PhD programs in the biomedical sciences.

In the last ten years, through its undergraduate research training programs, MSP has supported over 300 undergraduate UR students. Ninety-nine percent of them have graduated with a bachelor’s degree from UC Irvine. A large majority of students who completed the program have gone on to pursue a PhD. MSP students have co-authored more than 600 peer-reviewed publications in top journals including Science, Nature, Nature Neuroscience, Stroke, among others. MSP students have given more than 650 scientific presentations at national meetings, and have received more than 350 awards.
For more information, visit undergraduate.bio.uci.edu/minority-science-program/


Read through this entire welcome booklet.
Look for all the Peter the Anteater statues and benches across campus.
Learn more about your academic advising resources at undergraduate. bio.uci.edu/student-affairs
Walk, run or bike the Mountains to the Sea Trail.
Plan to attend at least half of the Dean’s Distinguished Lecture Series talks.
If you need some help with your studies, take advantage of the free Peer Tutoring program.
Introduce yourself to BioSci Dean Frank LaFerla and savor a pastry at “Donuts with the Dean.”
If you’re considering a health profession after graduation, attend a Pre-Health Workshop from Student Affairs.
Take a nap in Aldrich Park.
Study hard, but don’t be all work and no play. Make friends, explore new activities, exercise, eat right and get enough sleep. A well-balanced life will make you even more successful!
BIO SCI 93-93L
CHEM 1A
GE or Writing1
BIO SCI 2A
BIO SCI 94-94L
CHEM 1B
GE or Writing1
General Education
MATH 5A
CHEM 1C- 1LC
GE or Writing1
1Students have the option of taking HUMAN 1AS, HUMAN 1BS, HUMAN 1CS or WRITING 40, WRITING 50, WRITING 60 in order to fulfill the lower-division writing requirement.

UCIrvine Charlie Dunlop School of Biological Sciences Buildings Map
CHEM
General Education


@UCIBioSci
UC Irvine Charlie Dunlop School of Biological Sciences
@ucibiosci
UC Irvine Charlie Dunlop School of Biological Sciences
@UCIBioSci
@UCIBioSci

Dunlop School Student Affairs academic advisors equip students with the tools they need to have productive and meaningful college experiences – from the first summer orientation to the final walk at commencement. We partner with students and family members to share responsibility for student success.
• Take responsibility for your academic performance and experience. Your advisor is here to guide you as you make informed decisions for yourself.
• Take initiative to seek help before a situation becomes a crisis and advocate for yourself responsibly.
• Remember you are part of the larger UC Irvine community: be mindful of how your actions affect others. Be considerate of advisors, faculty, and classmates by being on time for appointments, preparing for classes, and respecting your peers.
• Do your part. Familiarize yourself with the academic calendar, be aware of important deadlines, and understand your degree requirements. If anything is unclear, remember that the most accurate information will come from your advisor.
• Be an active participant in the advising experience: think carefully about your academic and career plans and share your interests and goals with your advisor.
• Provide a supportive environment and build trusting relationships with students.
• Ask meaningful questions and listen to students to understand their strengths, challenges, and goals.
• Connect students with resources and opportunities to maximize their college experience and teach students skills to navigate the university.
• Respond promptly to student concerns, and use advising resources and knowledge to address students’ needs.
• Empower your student to take ownership of their college experience. Offer advice without making decisions for them.
• If you see your student is struggling, encourage them to check in with an academic advisor.
• Learn about campus resources and remind your student to use these resources and talk to academic advisors regularly.
Visit our website: https://undergraduate.bio.uci.edu
We value diverse perspectives and commit to civil discourse.
We strive to innovate, bravely take action, and learn from our mistakes.
We embrace diversity, uphold equity, and actively promote inclusion.
We hold ourselves and others responsible for our actions.
We commit to maintaining a collegial environment where everyone feels safe.
We work together and encourage collaboration.
We do what is right, even when it is difficult or no one is looking.
We set high standards and recognize both individual and collective achievement.

Come get yours on these dates and locations:
Monday, 9/23 BioSci Starbucks, 3-5 p.m.
Tuesday, 9/24 BioSci Starbucks, 10:00a.m.-12 p.m.
Wednesday, 9/25 Natural Sciences I, Room 1202, 9-11 a.m.
Thursday, 9/26 Natural Sciences I, Room 1202, 2-4 p.m.


